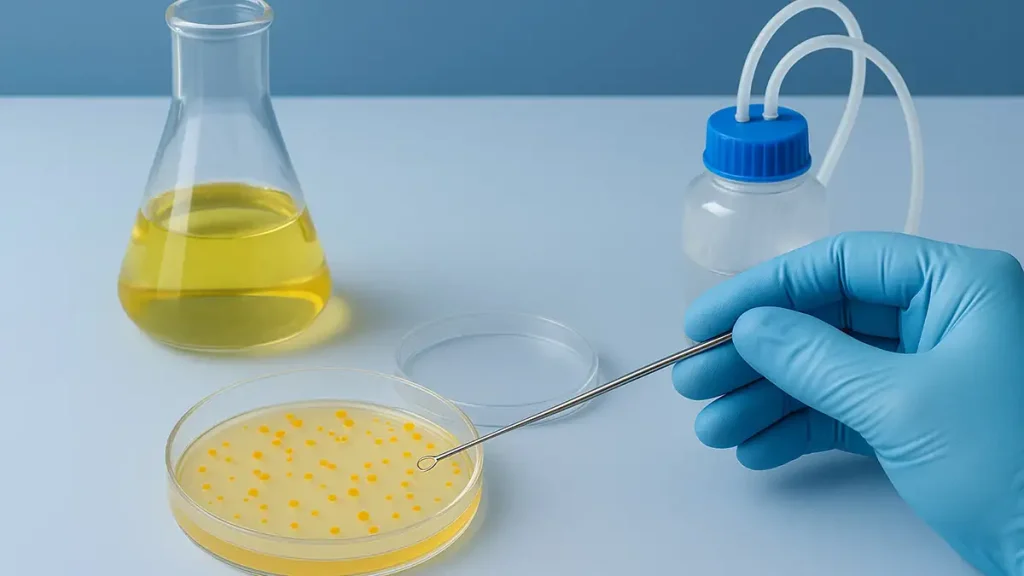
کشت میکروبی

زیست فناوری
مقالات زیست فناوری
مقالات زیست فناوری یکی از معیارهای مهم ارزیابی پیشرفت در این علم است. زیست فناوری کشاورزی یا همان گیاهی، نقش اساسی در تولید مواد غذایی انسان و همچنین دام و طیور دارد.
در اگرینت، تمرکز ما بر تولید مقالات کاربردی و قابل استناد برای فعالان بخش کشاورزی و زیست فناوری کشور است. کلیه مقالات و مطالب اگرینت کاملا تالیفی بوده و 100 درصد مالکیت اثر متعلق به بیوتکنولوژی کشاورزی اگرینت است.
بیوتکنولوژی کشاورزی
علم بیوتکنولوژی در کشاورزی به قدری نقش کلیدی دارد که تامین منابع تغذیه ای و امنیت غذایی همه مردم جهان به آن وابسته شده است. این وابستگی هر روز بیشتر و اساسی تر در زندگی روزمره خود را نشان می دهد.
با محدود شدن منابع طبیعی مانند منابع آبی و کمبود خاک حاصلخیز و فضای کافی برای کشت و کار از یک طرف و افزایش تقاضا برای محصولات کشاورزی از طرف دیگر، سبب شده تا اتکای بشر به تامین مواد غذایی برای انسان و سایر موجودات زنده مانند دام ها و نجات محیط زیست به بیوتکنولوژی باشد.
.